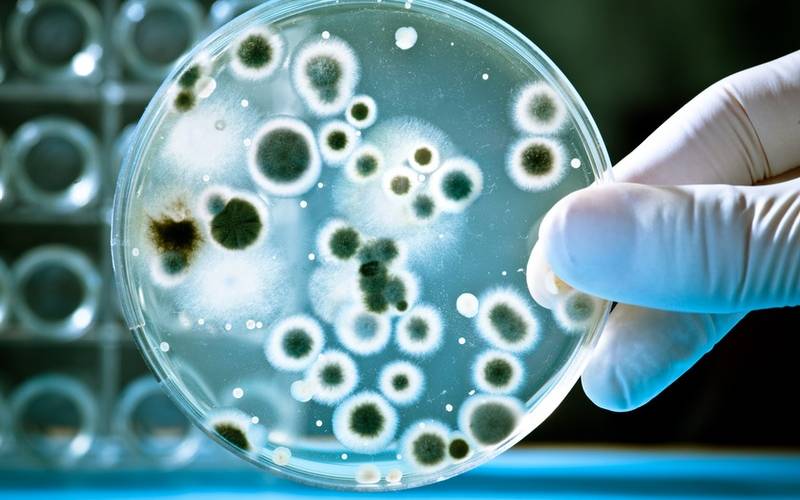

© Alexander Raths - Fotolia
© Alexander Raths - Fotolia
Tropenmediziner warnt vor Panikmache bei Coronavirus
Das Coronavirus aus China breitet sich weiter aus. Inzwischen gibt es einen ersten Fall in den USA. Der betroffene Mann war von einer Reise aus China zurückgekehrt. Dort ist die Zahl der infizierten Menschen bislang auf 440 gestiegen, neun Menschen starben bisher an der mysteriösen Lungenkrankheit.
Veröffentlicht: Mittwoch, 22.01.2020 05:27
Anzeige
Experten befürchten, dass sie sich auch nach Europa ausbreiten könnte. Dr. Arnd Giese - Tropenmediziner aus Herten - warnt aber vor Panikmache.
Anzeige
Anzeige
Heute will auch die Weltgesundheitsorganisation darüber beraten, ob eine Notlage ausgerufen werden soll. Dann wären besondere Maßnahmen zur Bekämpfung möglich, zum Beispiel Grenzkontrollen.
Anzeige